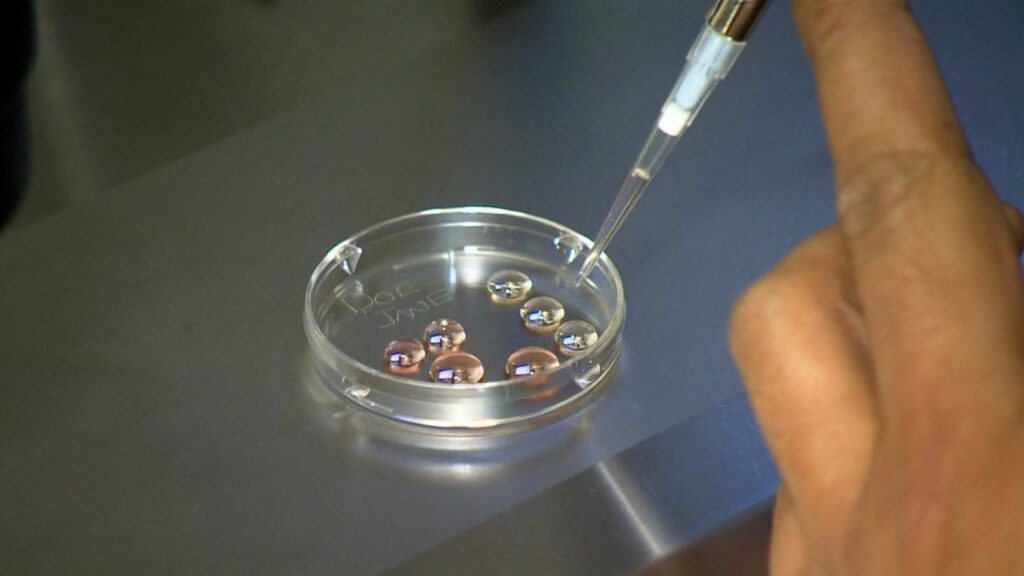

Nigerian music icon Tiwa Savage is encouraging women in their 30s to consider freezing their eggs, calling it a crucial form of “fertility insurance” that can reduce the pressure and uncertainty around delayed childbearing.
In a candid conversation with British media personality Zeze Mills, the 45-year-old Afrobeats star reflected on her own journey, revealing she wishes she had made the decision much sooner.
Savage, who welcomed her first child at age 34, said becoming a mother later in life was rewarding because she had reached a stage of financial security and emotional maturity.
“Having my first child in my 30s was beautiful because I was more financially and emotionally stable,” she said. “One advice I will give to women in their 30s is whether you wanna have children or not, ‘egg freeze.’”
Savage admitted that while she remains unsure about having more children, undergoing the procedure has given her peace of mind and flexibility.
“I wish I did it earlier. But I’ve done it now… just to have that insurance,” she added.
Her message comes amid a growing global conversation about reproductive health, with more women choosing to freeze their eggs as a way to preserve fertility and expand their options for future family planning.
By speaking openly about her own experience, Savage is helping to normalize discussions around egg freezing — a topic that has often been considered taboo in parts of Africa.
